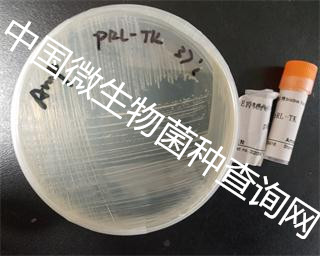
鼠伤寒沙门氏菌怎么传染给婴儿的 (培养基中鼠伤寒沙门氏菌如何计数)

鼠伤寒沙门氏菌SL1344-mCherry应带有质粒使其对Kan产生抗性,因此,在活化培养过程中应加入抗性防止染菌和因传代造成的质粒丢失(通常情况下不加抗性质粒也不容易丢失),在进行菌株荧光验证时,挑取单菌落至10mL LB培养基中,置于30℃,200rpm培养24小时(无需诱导),可见菌液变色,离心后肉眼可见。
一、菌株简介
平台编号:bio-108998
规格:1ml甘油菌加送一个平板
拉丁属名:Salmonella typhimurium SL-1344
中文名:鼠伤寒沙门氏菌SL1344-mCherry
抗性:卡那
培养基:LB 菌株类别:鼠伤寒沙门氏菌
培养条件:30℃,有氧,LB
保存方式::20%甘油,-20℃
可冻存1年,1年后取出重新活化保种
注意事项:仅用于科学研究或者工业应用等非医疗目的,不可用于人类或动物的临床诊断或治疗,非药用,非食用。
二、概述
鼠伤寒沙门氏菌,是一群非适应性或泛嗜性的沙门氏菌,具有广泛的宿主,是世界各国分离率最高的菌型之一。该菌能引起各种家禽和哺乳动物的传染病,也可引起人类感染,具有重要的公共卫生意义。
三、属性
属于沙门氏菌B群。O抗原有1,4,5,12,H抗原单相为1,双相为1,2。它是引起食物中毒而发生炎症的有名的细菌,但通过P22噬菌体转导、溶原化变换以及组氨酸操纵子等性状出现的调节机制的分析,也成为了促进微生物遗传学发展的一种重要的细菌。
四、分布与传播
本菌广泛分布自然界,存在于家禽、家畜、鼠类等多种动物的肠道。该菌在外界环境中抵抗力较强,常温下可迅速繁殖、耐低温、干燥、不耐热,55℃、1小时,60℃、25分钟即可灭活;对酸敏感,pH<2的酸性环境,99%被杀灭,对紫外线和各种化学消毒剂均敏感。
五、注意事项
1、为了您的安全和健康,请穿实验服并戴一次性手套操作。本产品仅可用于实验室研究,不能用于动物,人体以及作为食品添加剂等用途。
2、使用甘油菌时可不完全融解,在甘油菌表面蘸取少量涂布固体琼脂平板即可,也可完全融解后使用,但随着冻融次数的增加,菌株的活力会逐渐下降。
中国微生物菌种查询网作为中国微生物菌种中心引航者,单位代为引进美国ATCC微生物菌种保藏中心,德国DSMZ菌种保藏中心,荷兰CBS菌种保藏中心,日本JCM微生物菌种保藏中心,包括其中的ATCC微生物细菌与噬菌体(18382);细胞系和杂交瘤(4997);真菌和酵母(58183);原代细胞(146);原生动物和藻类(2428);干细胞(102);载体,克隆与分子(18006);病毒(3594);核酸 - DNA / RNA(1350),引进进口微生物菌种货期短,质量保证,UPS国际快递运输。